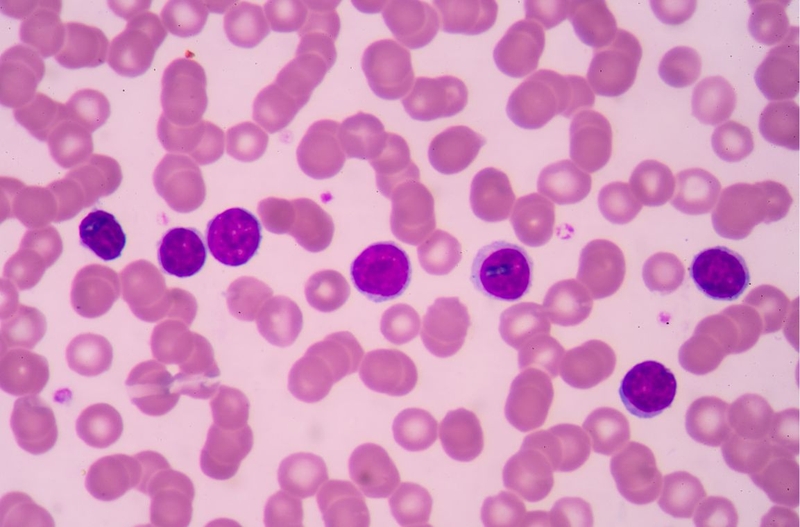
Tìm hiểu về hội chứng tăng sinh lympho bào liên kết X 1

Tốt nghiệp Khoa Dược trường Đại học Nam Cần Thơ. Có nhiều năm kinh nghiệm công tác trong lĩnh vực Dược phẩm. Hiện đang giảng viên cho Dược sĩ tại Nhà thuốc Long Châu.
Thanh Hương
21/02/2024
Mặc định
Lớn hơn
Hội chứng tăng sinh lympho bào liên kết X là một rối loạn vừa hiếm gặp, vừa phức tạp. Trong phạm vi bài viết này, Long Châu sẽ cùng bạn tìm hiểu khái niệm, nguyên nhân, triệu chứng và cách điều trị chứng tăng sinh lympho bào liên kết X.
Hội chứng tăng sinh lympho bào liên kết X hay hội chứng tăng sinh lympho liên kết với nhiễm sắc thể X là một rối loạn suy giảm miễn dịch gây đột biến gen nhiễm sắc thể X. Hội chứng này có thể dẫn đến suy gan, u lympho, bệnh tăng sinh lympho, bất sản tủy xương và có tỷ lệ tử vong khá cao.
Trong cơ thể con người có hệ thống tế bào miễn dịch bao gồm: Bạch cầu trung tính, bạch cầu ưa kiềm, bạch cầu ưa axit, bạch cầu đơn nhân mono, tế bào mast, đại thực bào, tế bào diệt tự nhiên tế bào đuôi gai và tế bào lympho. Lympho là một trong những tế bào bạch cầu quan trọng của hệ miễn dịch. Nó được sinh ra từ lá lách, hạch bạch huyết, tuyến ức và tủy xương.
Tế bào lympho gồm tế bào lympho T và tế bào B có nguồn gốc từ tế bào gốc trong tủy xương. Ngoài ra, tế bào lympho còn có một loại khác tên là lympho NK có chức năng chống lại tế bào ung thư và đáp ứng nhanh với các chất lạ xâm nhập vào cơ thể. Nồng độ các tế bào lympho trong cơ thể con người là khác nhau, tùy theo giới tính, khu vực sinh sống, thói quen sinh hoạt thậm chí là chủng tộc. Tuy nhiên, nó sẽ dao động từ 3000 - 9500 tế bào/1 μL máu đối với trẻ em và 1000 - 4800 tế bào/1 μL máu đối với người lớn.
Hội chứng tăng sinh lympho bào liên kết X hay còn được gọi là hội chứng tăng sinh lympho liên kết với nhiễm sắc thể X (viết tắt là XLP ) là rối loạn suy giảm miễn dịch xảy ra khi có khiếm khuyết của các tế bào lympho T và tế bào tiêu diệt tự nhiên. Hội chứng này đặc trưng bởi các đáp ứng bất thường của hệ miễn dịch cơ thể với virus Epstein-Barr gây ra suy giảm miễn dịch, suy gan, u lympho, bệnh tăng sinh lympho gây xương bất sản hoặc tử vong,...
Hội chứng này chỉ xảy ra ở nam giới và được phân thành 2 loại gồm:
Hội chứng tăng sinh lympho liên kết với nhiễm sắc thể X thường không có triệu chứng rõ ràng. Chỉ đến khi người bệnh nhiễm virus EBV và phát triển thành bệnh suy gan hoặc bệnh Mono (Mononucleosis) - bệnh bạch cầu đơn nhân nhiễm khuẩn, bệnh mới được phát hiện.

Hội chứng tăng sinh lympho bào liên kết X chưa xác định được nguyên nhân cụ thể, chính xác và đầy đủ hoàn toàn. Tuy nhiên, giới chuyên môn cho rằng một số yếu tố dưới đây có liên quan trực tiếp đến quá trình phát triển của hội chứng:

Tùy nguyên nhân và mức độ nghiêm trọng của hội chứng XLP, các triệu chứng được biểu hiện trên từng bệnh nhân là khác nhau. Một số triệu chứng thường gặp nhất như:
Điều trị hội chứng tăng sinh lympho bào liên kết X là điều trị đa lĩnh vực. Đây là một hội chứng cực kỳ nguy hiểm với tỷ lệ bệnh nhân tử vong trước 10 tuổi lên đến 75% và hầu hết người bệnh đều qua đời cho đến khi trung tuổi. Phương pháp duy nhất để điều trị hội chứng này là ghép tế bào gốc. Phương pháp này đã mang lại sự sống cho khoảng 80% người bệnh. Các phương pháp hiện đang được áp dụng trong điều trị hội chứng XLP như:

Hội chứng tăng sinh lympho bào liên kết X là tình trạng hiếm gặp và nguy hiểm, cần can thiệp và điều trị sớm. Nguyên nhân dù chưa xác định rõ ràng nhưng có nhiều yếu tố được xác định là mang tính nguy cơ cao. Ngoài việc căn cứ nguyên nhân gây hội chứng để có giải pháp phòng ngừa, kiểm soát phù hợp, khi có triệu chứng bất thường, chúng ta nên đi khám chuyên khoa sớm. Chỉ cần điều trị đúng phương pháp, có đến 80% người mắc hội chứng XLP có thể bảo toàn tính mạng.
Dược sĩ Đại họcNguyễn Thị Thảo Nguyên
Tốt nghiệp Khoa Dược trường Đại học Nam Cần Thơ. Có nhiều năm kinh nghiệm công tác trong lĩnh vực Dược phẩm. Hiện đang giảng viên cho Dược sĩ tại Nhà thuốc Long Châu.